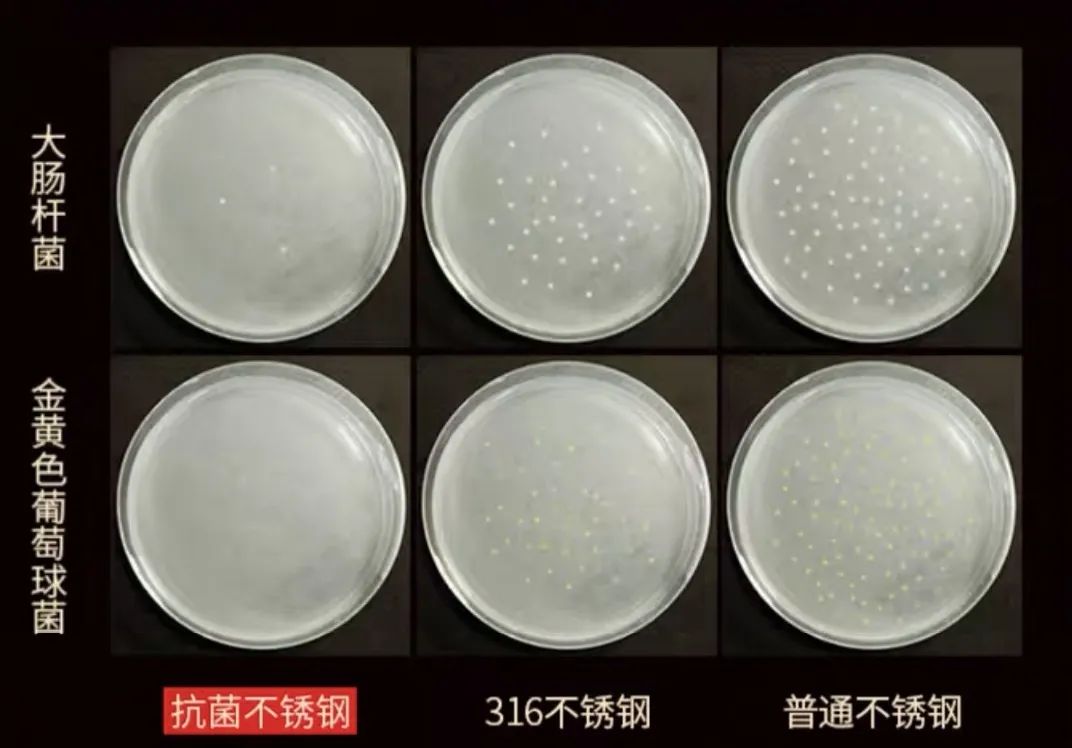
菜板保护,菜板好用又健康

很多人认为年龄较大和生活方式不健康的人才是结肠癌的高危人群。
其实,病菌也是结肠癌的诱因之一。大肠杆菌会穿透结肠表面粘膜层,释放毒物损坏结肠中细胞的DNA,初期会导致腹泻、呕吐、食欲不振,严重时会诱发结肠癌等病症。

据国家癌症钟心2018年发布的中国zui新癌症数据显示,结直肠癌位居我国发病率和死亡率第四位。
而且,美国研究者发现,结直肠癌的平均患者年龄正在持续降低。越来越多二、三十岁出头的年轻人开始患上这种所谓的“老年病”。

俗话说“病从口入"。我们平时做饭的地方,潜藏着各种病菌,这些病菌会随着食物被我们吃进肚中,从而诱发各种病症。
你有没有发现,买回家的菜板没用几次,上面就布满了坑坑洼洼的刀痕,用上一段时间甚至发霉了!!
菜板上肉眼可见的长毛或者黑斑多半是黄曲霉菌,黄曲霉菌是一种腐食霉菌,它被列为一及致癌物,会增加癌症风险。

食物上一旦被发现长了黄曲霉菌,专家都建议整个丢掉的!所以,这种易发霉的菜板你还敢用吗?!

除了肉眼可见的病菌外,菜板上还有更多像大肠杆菌这种看不见的病菌。曾有人做过实验,一公分菜板上可能有高达2亿个病菌。

很多病因都源于不起眼的小细节,为了自己和家人的身体健康,快丢掉那块发霉的菜板吧。
今天给你分享一款BOMS博曼斯的双面菜板,速干不发霉,用它给家人做饭超安心。

这款菜板一块能当两块,可分类使用,避免鱼肉中的寄生虫交叉赶染。

用完后水一冲就干净了,避免食物残渣衍生病菌,长期使用也不会滋生霉菌。

有了这块菜板,可以降低“病从口入”的风险,长时间使用也不会成为身体的负担。关键是家人吃得健康,少生病,我们也能少操心。

扛菌菜板 菜板中的“an全卫士”
很多人会定期对餐具高温肖毒,甚至买个消毒柜来保证餐具健康,可却忽略了常用的菜板。
电视台曾做过一项测试,节目组分别收集了竹板、木板、塑料板。然后将这三块菜板带到医院做病菌培养。

为了对比菜板上的病菌程度,他们还请医生在厕所做了采样。
测试结果证明:我们每天都在用的这几种菜板,病菌竟然比马桶还要多!这些病菌不仅会导致腹泻、呕吐,还会增加癌症的风险。

虽然新闻曝光了,可商超里卖的菜板大多还是以木、竹、塑料为主,无法避免这些隐患。
不少人还认为用开水对菜板进行肖毒,然后再用洗洁精洗一遍,就能洗掉菜板中的病菌。

黄曲霉菌耐280°高温,家里的开水还远远达不到能泡死它的温度。而且木质和塑料菜板中的甲醛、塑料剂也是开水溶解不掉的,这些有害物质都会随餐进腹,成为健康隐患。

综合对比后,小编才选择了这款BOMS的双面菜板,用起来更放心。

双面YI 菌 健康有保障
普通菜板用完会有很多刀痕,这些刀痕凹槽内的残留物很难清洗,时间一长就成了“病菌的温床”,会迅速衍生大量的病菌。

虽说洗洁精可以洗掉一部分病菌,但刀痕里会残留更多洗洁精的“化学残留物”,对身体同样有害。
BOMS的Yi菌菜板采用PP环保材质(婴儿奶瓶级材质)和304扛菌不锈钢,用力剁肉、切菜都不会有很深的刀痕。

不锈钢中的CU防霉金属元素会破坏病菌的细胞壁,使其无法生长和繁殖。

官方曾做过一项测试,取出一些病菌,分别放在304扛菌不锈钢、316不锈钢和普通不锈钢的器皿中,24小时后304扛菌不锈钢器皿中的病菌明显比其他两个器皿少。
(*数据来源于中国科学院材料实验室)
有了这块菜板,再也不用担心菜板里面的病菌剁到食物里了,吃起来更健康。

易冲洗无残留 速干不发霉
普通的木头菜板湿水后会变潮湿,干起来很慢,非常容易滋生大肠杆菌、霉菌等病菌。
会吸水的砧板也很容易染色,切菜时血水、果汁都会附在菜板上,很难清洗掉,而且食材之间容易串味。

BOMS菜板的密度结构紧密,双面材质都不会吸水,可以避免汁水和病菌侵蚀。
易染色的火龙果果渣,用清水轻轻一冲就干净了,不用担心染色、残留问题。
切完菜后,挂起来或立起来,不到10分钟就能晾干,不给病菌滋生留机会。

菜板里面使用了麦秸秆夹层,麦子的茎秆能保护粮食在水稻里不被微生物腐蚀和虫蛀。
制作工艺上采用高温高压一体成型,高密度无孔不吸水,从源头解决发霉问题。

菜板比普通菜板更经用,一块至少可以用2-3年,省心还省钱。用过的顾客都一致给出了好评⬇️

多功能菜板=双面菜板+磨刀石
菜板的使用上有两条原则:生熟两用,肉菜分开,每个家庭至少需要2-3块菜板。但是菜板多了占地方,洗起来也麻烦。
BOMS这款双面菜板,双面都能用,一面切生食,一面切熟食。

304扛菌不锈钢这面可以用来切生食,剁骨不伤刀,还能去鱼腥、除异味,保留食材的自然风味。

304不锈钢表面与空气接触时释放出来的铁离子,会将异味分子芬解还原成无味状态,用来切荤菜zui适合不过了。
PP环保材质面可以用来切熟食,水果。

菜板四周添加了防溢水凹槽设计,汁水会顺着网格流进凹槽里,防止汁水流的到处都是。

切菜时zui糟心的事莫过于,菜还没切完,刀却先钝了。
BOMS菜板自带磨刀石,可以即时解决钝刀烦恼。只要握住刀柄,单向后拉数次,刀刃就能变锋利,切菜更加畅快。


人性化设计 使用感满分
传统的菜板容易滑动,切易滑的食物,很容易切到手。BOMS菜板采用防滑网络纹理 ,增强食物与菜板的摩擦,避免切到手。

比普通菜板更厚,也会稍微重一些,但是更稳固,砍排骨、剁猪蹄时不会抖动。

采用TPR包边降音(降音耳*机使用材质),切菜时发出的声音更小,不会影响家人休息。

菜板上有个圆边防滑提手,用完之后可以挂在厨房的钩子上,不占地儿。
两种尺寸可供选择,独居或情侣用中号就够了,两人以上建议选择加大款。

《申》报热销商品


